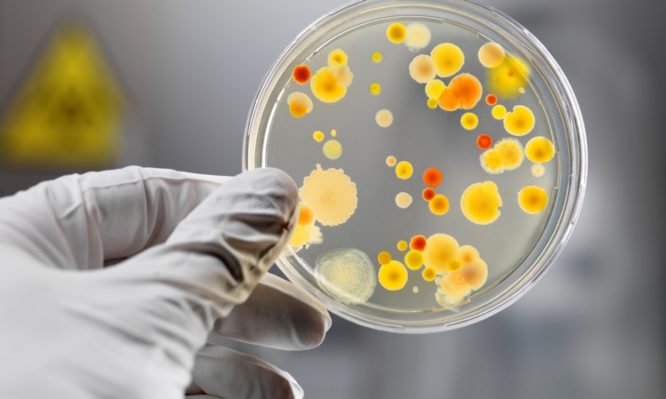

Δημιούργησαν συνθετικό αντιβιοτικό που εξοντώνει τα πιο ανθεκτικά βακτήρια
Ένα νέο αντιβιοτικό, το οποίο υπερνικά διάφορες μορφές αντιμικροβιακής αντοχής, δημιούργησαν επιστήμονες στις ΗΠΑ. Το συνθετικό φάρμακο λέγεται κρεζομυκίνη (cresomycin) και πειράματα έδειξαν ότι εξοντώνει πολυανθεκτικά βακτήρια όπως:
- Ο χρυσίζων σταφυλόκοκκος
- Η ψευδομονάδα η πυοκυανική (pseudomonas aeruginosa)
- Το κολοβακτηρίδιο (escherichia coli)
Τα δύο πρώτα από αυτά τα βακτήρια ανήκουν στην επονομαζόμενη λίστα με τα παθογόνα προτεραιότητας του Παγκόσμιου Οργανισμού Υγείας (ΠΟΥ). Στον κατάλογο αυτό έχουν ενταχθεί τα βακτήρια για τα οποία υπάρχει επείγουσα ανάγκη για νέα αντιβιοτικά.
Η αντοχή των μικροβίων (βακτηρίων) στα αντιβιοτικά είναι μία από τις μεγαλύτερες απειλές για τη δημόσια υγεία. Υπολογίζεται ότι κάθε χρόνο προκαλεί περισσότερους από 35.000 θανάτους στην Ευρωπαϊκή Ένωση.
Το νέο, συνθετικό αντιβιοτικό δημιούργησαν στο εργαστήριο επιστήμονες από το Πανεπιστήμιο Χάρβαρντ. Όπως αναφέρουν, ο ρυθμός ανακάλυψης νέων, αποτελεσματικών αντιβιοτικών υπολείπεται του ρυθμού εξάπλωσης των ανθεκτικών μικροβίων σε όλο τον κόσμο. Και αυτό διότι τα τροφοδοτεί η συνεχιζόμενη κατάχρηση των αντιβιοτικών.
Το νέο αντιβιοτικό
Η ανάπτυξη του νέου αντιβιοτικού και τα ευρήματα των δοκιμών του στο εργαστήριο δημοσιεύθηκαν στην επιστημονική επιθεώρηση Science.
Όπως εξηγούν οι ερευνητές, το φάρμακο που δημιούργησαν είχε ως έμπνευση μία οικογένεια αντιμικροβιακών σκευασμάτων που λέγονται λινκοζαμίδες. Σε αυτήν ανήκει, λ.χ., το παλαιό αντιβιοτικό κλινδαμυκίνη (clindamycin) που χορηγείται για την αντιμετώπιση σοβαρών βακτηριακών λοιμώξεων.
«Τα ευρήματά μας έδειξαν ότι το φάρμακο που αναπτύξαμε ασκεί σημαντικά βελτιωμένη ανασταλτική δράση έναντι σειράς παθογόνων βακτηρίων που σκοτώνουν ετησίως περισσότερους από 1 εκατομμύριο ανθρώπους σε όλο τον κόσμο», δήλωσε ο επιβλέπων ερευνητής Dr. Andrew Myers, καθηγητής Χημικής & Χημικής Βιολογίας στο Χάρβαρντ.
Οι σχετικές έρευνες στο εργαστήριο έδειξαν ότι το αντιβιοτικό δεν αναστέλλει την ανάπτυξη βασικών ενζύμων που διαθέτουν τα ανθρώπινα κύτταρα για να λειτουργούν. Επιπλέον, τα πειράματα σε ζώα ήταν ενθαρρυντικά ως προς την αποτελεσματικότητά του.
Για να αποκλειστεί, όμως, το ενδεχόμενο να είναι τοξικό, απαιτούνται πολλές ακόμα έρευνες. Όταν αυτές ολοκληρωθούν, θα ελεγχθεί η ασφάλεια και η αποτελεσματικότητά του σε ανθρώπους.
Φωτογραφία: iStock







